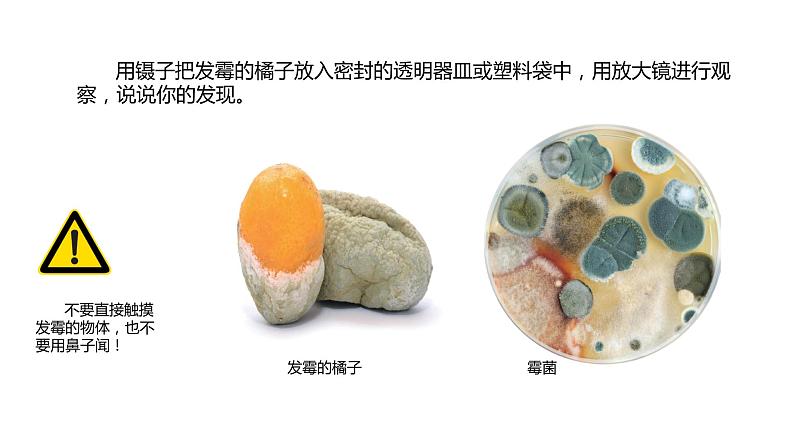
1.3发霉与防霉（课件）2021-2022学年五年级科学下册苏教版第6页
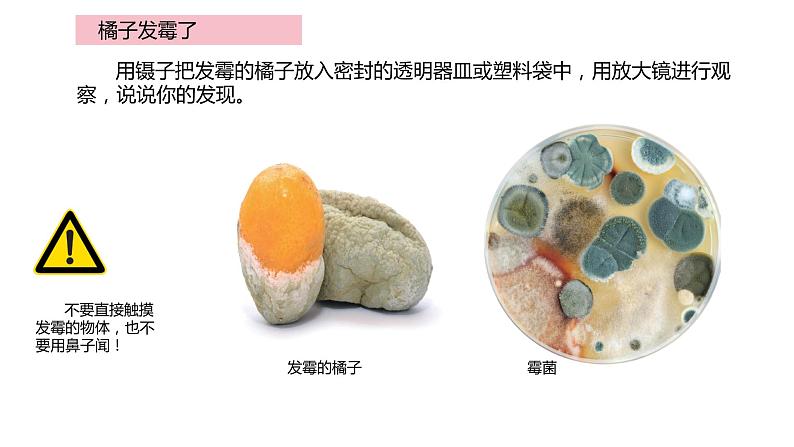
1.3发霉与防霉（课件）2021-2022学年五年级科学下册苏教版第8页

2021学年第一单元 显微镜下的生命世界3 发霉与防霉完整版ppt课件
展开
这是一份2021学年第一单元 显微镜下的生命世界3 发霉与防霉完整版ppt课件,共19页。PPT课件主要包含了防霉方法,橘子发霉了,发霉的环境,霉菌的生活环境,花盆里既潮湿又阴暗,防霉的方法等内容,欢迎下载使用。
掉下来的橘子已经发霉了。用放大镜能看清楚霉是什么样子的吗?
在生活中,我们常会看到食物或衣物发霉的现象。发霉是由于霉菌的大量 繁殖和生长引起的。霉菌个体较小,要使用放大镜或显微镜进行观察。
用镊子把发霉的橘子放入密封的透明器皿或塑料袋中,用放大镜进行观 察,说说你的发现。
发霉的橘子 霉菌
不要直接触摸发霉的物体,也不要用鼻子闻!
植物和动物的生存都需要一定的条件,如水分、空气、阳光等。霉菌的生长繁殖是否也需要一定的条件? 寻找身边哪里有发霉的物品,记录霉菌生活环境的特点。
寻找身边哪里有发霉的物品,记录霉菌生活环境的特点。
为什么靠近窗口的墙壁容易发霉?
依次用放大镜和显微镜仔细观察物品上的霉。说说不同物品上的霉有什么相同和不同之处。
探究物品发霉的条件
根据霉菌生长所需的条件,我们可以采取哪些有效防止物品发霉的措施?
相关课件
这是一份小学科学苏教版 (2017)五年级下册3 发霉与防霉完美版ppt课件,文件包含苏教版科学五年级下册13《发霉与防霉》课件pptx、苏教版科学五年级下册13《发霉与防霉》教案docx、1显微镜的使用wmv、制作和观察霉菌切片wmv等4份课件配套教学资源,其中PPT共16页, 欢迎下载使用。
这是一份苏教版 (2017)五年级下册3 发霉与防霉优质ppt课件,文件包含苏教版科学五下53《发霉与防霉》课件pptx、苏教版科学五下53《发霉与防霉》教案docx等2份课件配套教学资源,其中PPT共25页, 欢迎下载使用。
这是一份苏教版 (2017)五年级下册3 发霉与防霉精品教学课件ppt,文件包含苏教版科学五年级下册13发霉与防霉教学课件pptx、苏教版科学五年级下册13防霉和发霉同步教案docx等2份课件配套教学资源,其中PPT共16页, 欢迎下载使用。










